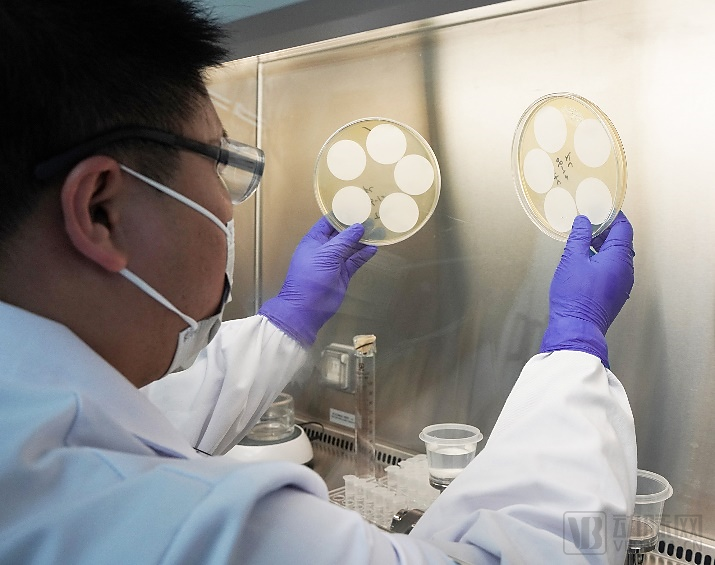

动脉网获悉,近日,艾里奥斯生物科技(上海)有限公司(以下简称“艾里奥斯”)宣布完成近亿元A轮融资。本轮融资由经纬创投和君联资本共同领投,上海羿水流山等投资方跟投,羿山资本担任本次融资战略融资顾问。本轮融资资金将用于艾里奥斯膜材研发中心建设、制药工艺用过滤器产品生产基地建设与规模提升、以及专业人才团队扩充等方面。
艾里奥斯成立于2021年,专注于制药过程工艺配套技术产品的开发和应用,并致力于为制药企业提供符合国内外法规要求的高质量的分离、纯化解决方案。
艾里奥斯参考GMP要求自建了位于上海临港和杭州的生产基地,拥有工艺开发实验室、验证实验室、以及过滤产品研发中心,并建立了膜技术科学家领头的研发团队,以更好地保障中国制药企业的供应链安全,帮助用户优化药物研发和生产工艺,提高药品的生产安全性。艾里奥斯秉着协作、诚信、尊重、责任的企业价值观,助力中国制药企业的创新发展。正如“艾里奥斯”名字的寓意,艾里奥斯致力成为全球制药工艺产业链中闪耀的一颗星。


艾里奥斯创始人兼董事长贾启军表示,“伴随着中国生物制药产业的蓬勃发展,产业链上游的生物工艺市场呈现高速增长态势,作为生物工艺下游核心之一的膜过滤,其全球市场规模在2021年已超过400亿元,国内市场近40亿元。生物工艺膜过滤技术横跨《中国制造2025》战略中“新材料”和“生物医药”两大领域,如何做好两个领域的技术转化和产业链接,是突破该领域“卡脖子”技术的关键。艾里奥斯自创立之初,便开始积极组建相关领域的专家团队,以创新驱动、质量为先的理念方针,旨在打造具有自主知识产权、高质量的膜过滤产品和解决方案,希望为中国高端制造和中国生物制药的发展贡献自己的一份力量。”

经纬创投董事总经理孙凌皓表示:“艾里奥斯是我们在生命科学工具的又一早期布局。公司主要团队全部来自于生物医药膜过滤领域的顶尖外企,成立不久便已在上海临港及杭州下沙建立了符合标准的生产基地,完成多家主流客户的产品验证。在后疫情时代,我们认为对于客户工艺的专业理解和底层材料的研发能力是未来长期竞争的核心。期待艾里奥斯团队能够持续推出高质量产品,为保障我国生物医药上游核心供应链的安全稳定做出贡献。”
君联资本董事总经理汪剑飞表示:“国内制药行业的高速发展提升了制药关键过滤耗材的市场需求,国际贸易争端和新冠疫情使本土生物药企业急需稳定供应链,集采成本压力驱动本土药企追求高性价比的过滤工艺解决方案;目前外资企业仍占制药过滤耗材行业重要市场份额,本土企业具有较大发展空间;艾里奥斯创始团队和骨干配合默契,执行力强,其深耕生物制药耗材行业十余年,熟悉制药工艺和过滤技术,了解市场需求和客户痛点,并具备多年精益生产管理经验;公司多个产品已初步推向市场,客户反馈积极;我们相信艾里奥斯在资本助力下将加速发展、不断努力精进,我们君联资本也将继续在公司发展战略优化、管理运营支持以及产业连接合作等方面提供帮助。”
经纬创投创立于2008年,是行业内长期专注早期和早成长期投资的头部创投机构,专注新技术、硬科技、产业数字化、医疗、前沿科技、新消费等领域投资。目前累计投资700多家企业,小鹏汽车、理想汽车、富途证券、车好多集团、饿了么、容百科技、极米科技、陌陌、PingCap、沛嘉医疗、北森、自嗨锅、简爱、镁伽机器人、恩和生物、艾棣维欣等。
君联资本成立于2001年4月,是联想控股旗下专注于早期风险投资及成长期私募股权投资的基金管理公司。在二十年的发展历程中,君联资本遵循国际通行标准,创造基金运营及管理的最佳实践。君联资本通过积极主动的增值服务体系,推动企业创新成长,在多个投资领域持续创造良好投资回报的同时,推动中国的产业进步和社会发展。君联资本以“成为一家具有国际影响力的投资公司”为愿景,秉承“富而有道”的核心价值观,积极践行社会责任。
*市场数据来源:Allied Market Research市场研究报告
想要联系动脉网报道的企业,请点击文末左下方“阅读原文”填写表单,我们的工作人员将征求企业意见后,尽快为您服务。




个人中心
我是园区


